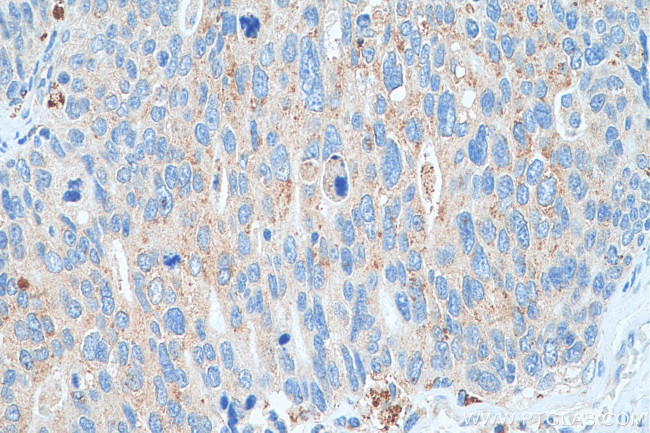
EPX Antibody in Immunohistochemistry (Paraffin) (IHC (P))

Search
Proteintech
EPX Polyclonal Antibody
{{$productOrderCtrl.translations['antibody.pdp.commerceCard.promotion.promotions']}}
{{$productOrderCtrl.translations['antibody.pdp.commerceCard.promotion.viewpromo']}}
{{$productOrderCtrl.translations['antibody.pdp.commerceCard.promotion.promocode']}}: {{promo.promoCode}} {{promo.promoTitle}} {{promo.promoDescription}}. {{$productOrderCtrl.translations['antibody.pdp.commerceCard.promotion.learnmore']}}
产品信息
29755-1-AP
种属反应
宿主/亚型
分类
类型
抗原
偶联物
形式
浓度
规格
纯化类型
保存液
内含物
保存条件
运输条件
产品详细信息
Immunogen sequence: LSQPRNLAQL SRVLKNQDLA RKFLNLYGTP DNIDIWIGAI AEPLLPGARV GPLLACLFEN QFRRARDGDR FWWQKRGVFT KRQRKALSRI SLSR
靶标信息
EPX belongs to the peroxidase family, XPO subfamily. Defects in EPX are the cause of eosinophil peroxidase deficiency (EPD).
仅用于科研。不用于诊断过程。未经明确授权不得转售。
篇参考文献 (0)
生物信息学
蛋白别名: Eosinophil peroxidase; EPO; EPX PEN; PERE
基因别名: EPER; EPO; EPP; EPX; EPX-PEN; EPXD
UniProt ID: (Human) P11678, (Mouse) P49290
Entrez Gene ID: (Pig) 100514365, (Human) 8288, (Mouse) 13861